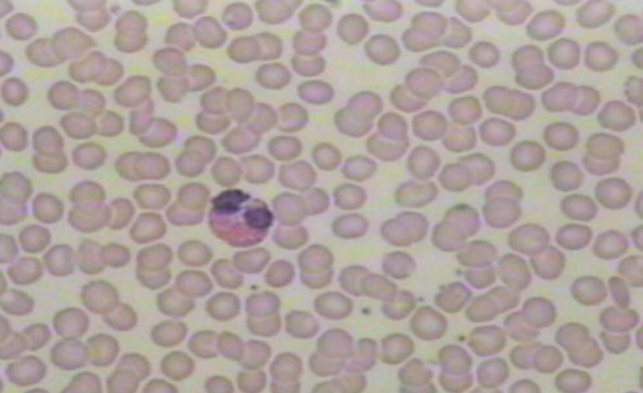

Histology Lab Extra Credit
1/15
Earn XP
Description and Tags
Study Location and function
Name | Mastery | Learn | Test | Matching | Spaced |
|---|
No study sessions yet.
16 Terms
simple squamous epithelium
Location: Line/covers most abdominal organs
Function: Quick diffusion & reduces friction

simple cuboidal epithelium
Location: Glands, ovaries, and kidneys
Function: Secretion and absorbs

simple columnar epithelium
Location: Lining of the digestive tract (stomach)
Function: Protect, absorb, and secrete

pseudostratified epithelium
Location: Respiratory tract and oviducts
Function: To move materials along the outer surface of the cell

stratified squamous epithelium
What makes it tough? Keratin
Location: Lining of the mouth, anus, and vagina
Function: To secrete and protect

skeletal muscle
Location: found attached to bones

cardiac muscle
Location: Found only in the heart

smooth muscle
Location: Walls of hollow organs

loose connective tissue
Know as? Areolar tissue
Name of yellow fibers? Elastin
Location: Under the skin
Function: To attach skin to tissues and cushion organs

adipose
What substance is stored? Fat
Location: Under skin, behind eyes, kidneys, abdominal membranes
Function: Insulate, pad and as a heat energy reserve

dense regular
Name of white fibers? Collagen fibers
Location: Tendons, ligaments, white part of the eye

hyaline cartilage
What cells produce this tissue? chondrocytes
Location: End of boNes, trachea rings, costal (ribs)
Function: Support and cushioning

fibrocartilage
Location: intervertebral disc, hips and knee joints
Function: Absorb compressive shock

bone
What cells produce this tissue? Osteocytes
Location: Skeleton
Function: Support, attachment sites, levers for movement and mineral storage
blood
Matrix of this tissue? Plasma
Function: Transport gases, nutrients and waste
nervous tissue
What cells support this tissue? Neuroglia
Location: Brain, spinal cord, and peripheral
